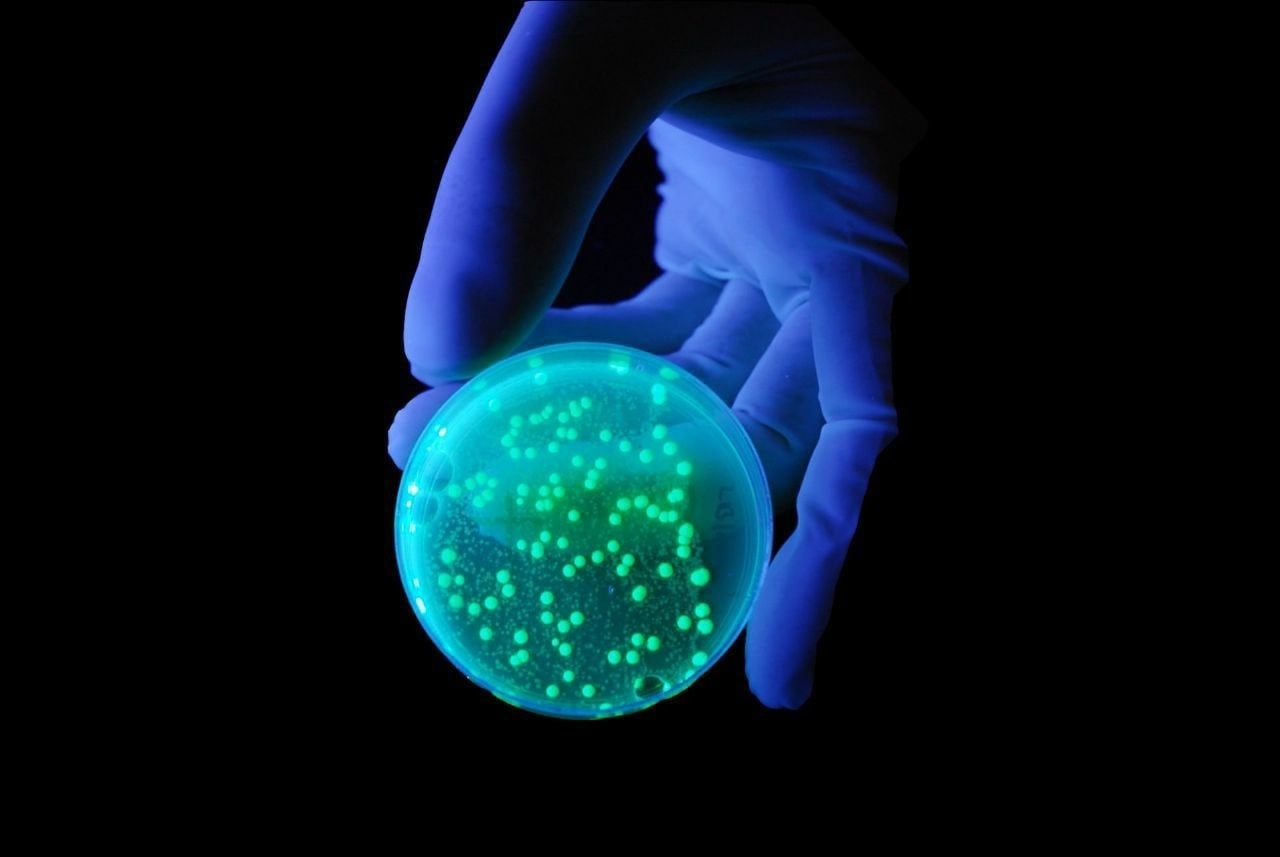

Флуоресцентные зонды
Узлы скатов кровли
Кто выбил выжить в дубае
Будка тойота
Я и моя стая
Хоррор мод сиреноголовый
Еврейский новый год сегодня
Клинок рассекающий демонов танджиро шипы
Линейный разъединитель рлк 10
Умерший отец поцеловал
Схема подключения контактора пуск стоп
Завод шмидта
Программа меняющая цвета
Acer 3 sf314 511
Флуоресцентные зонды 113 фото